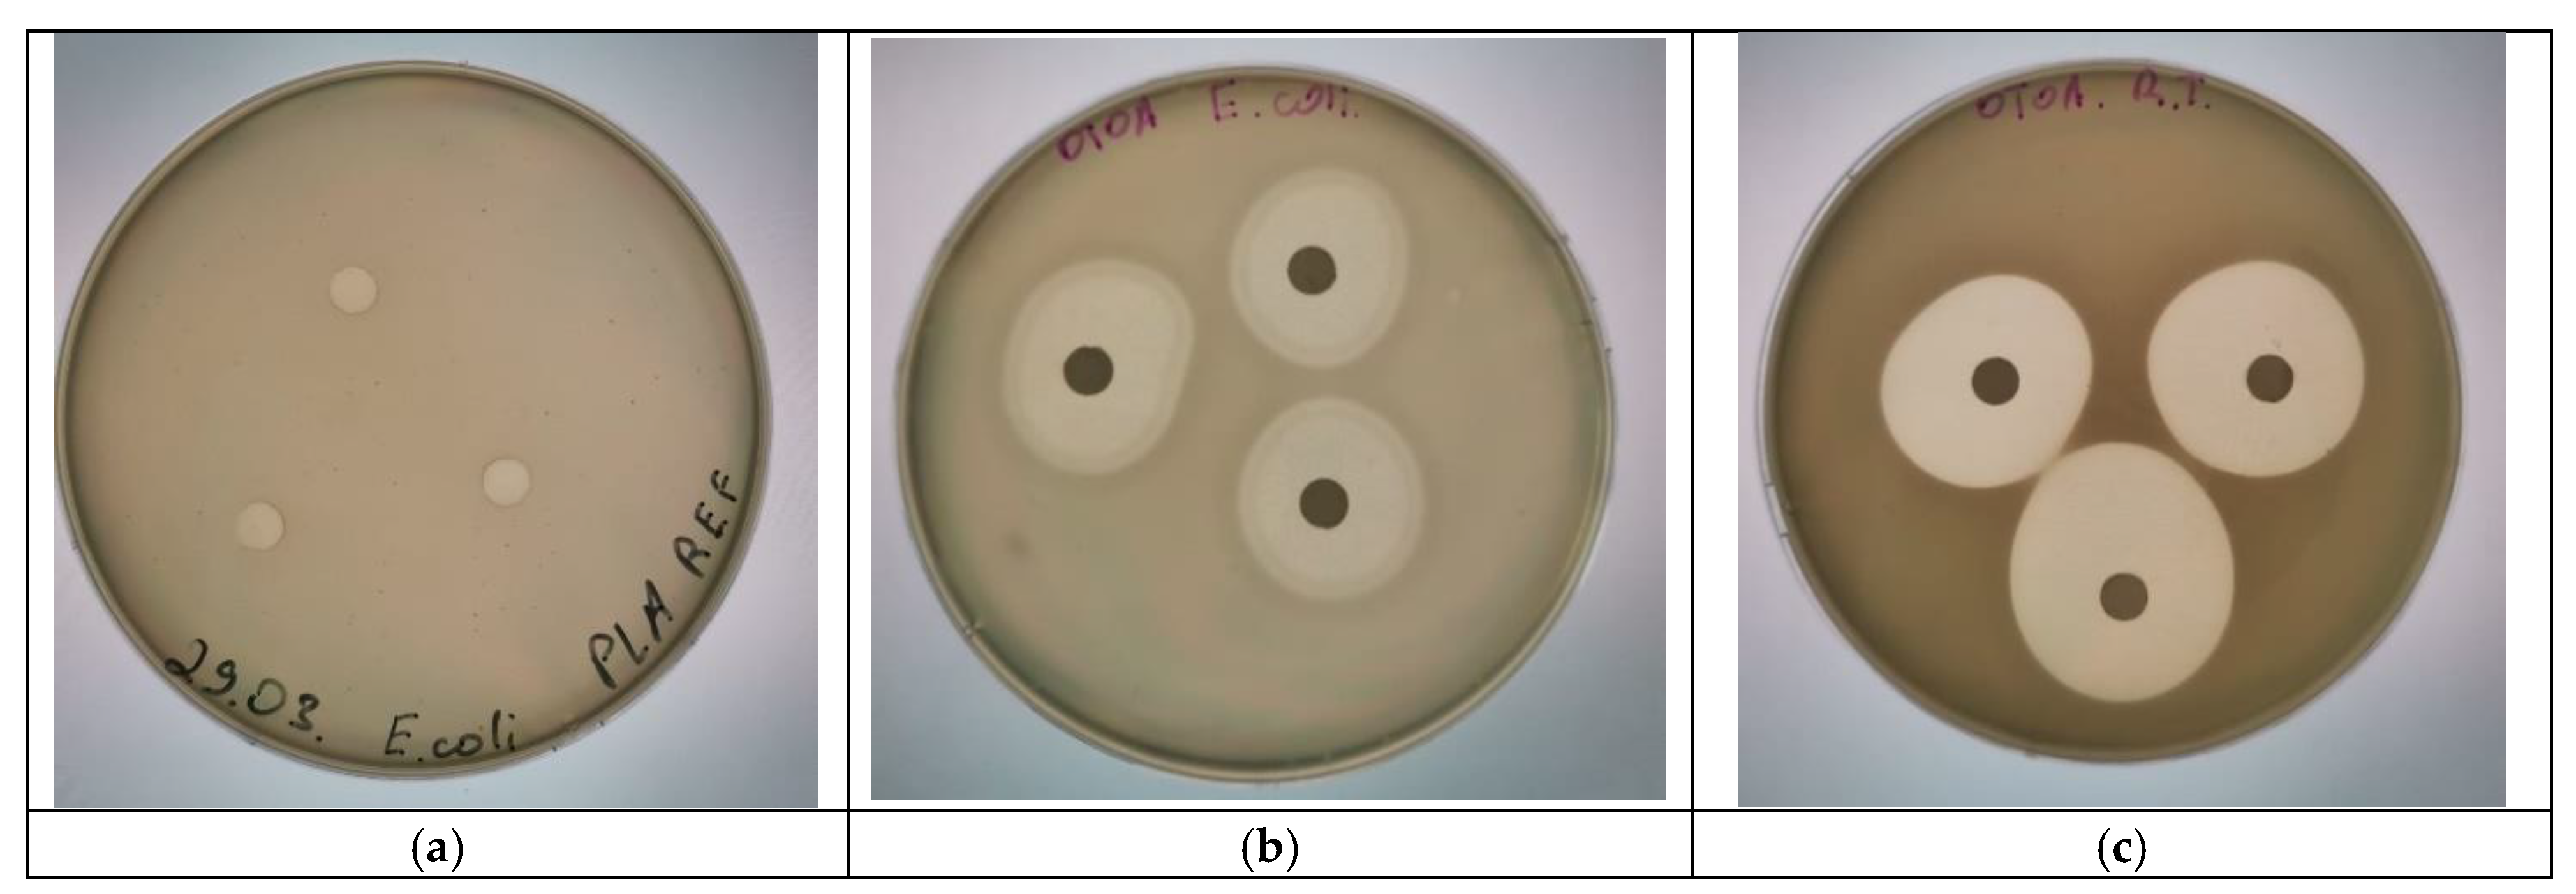
Polymers 16 03554 g008

Characterization and Evaluation of Zero-Order Release System Comprising Glycero-(9,10-trioxolane)-trialeate and PLA: Opportunity for Packaging and Biomedicine Applications
Abstract
1. Introduction
2. Materials and Methods
2.1. Materials
2.2. Preparation of Films
2.3. OTOA Release Studies
Analysis of Drug Release Data Using Mathematical Models
2.4. Morphology and Opacity of PLA Films
2.5. FTIR Spectroscopy Measurements
2.6. X-Ray Diffraction Analysis
2.7. Differential Scanning Calorimetry
2.8. Mechanical Properties of PLA Films
2.9. Measurements of Antibacterial Activity
3. Results and Discussion
3.1. OTOA Release from PLA Films
3.2. Morphology of PLA Films
3.3. FTIR Spectroscopy
3.4. XRD
3.5. DSC
3.6. Mechanical Properties of the Films
3.7. Antibacterial Activity of the PLA + 50% OTOA Films
4. Conclusions
Author Contributions
Funding
Institutional Review Board Statement
Data Availability Statement
Conflicts of Interest
References
- Shaili, V.; Khan, S. A Critical Analysis of the Rising Global Demand of Plastics and its Adverse Impact on Environmental Sustainability. Environ. Pollut. Manag. 2021, 3, 105. [Google Scholar] [CrossRef]
- Andler, R.; Tiso, T.; Blank, L.; Andreeßen, C.; Zampolli, J.; D’Afonseca, V.; Guajardo, C.; Díaz-Barrera, A. Current progress on the biodegradation of synthetic plastics: From fundamentals to biotechnological applications. Rev. Environ. Sci. Bio/Technol. 2022, 21, 829–850. [Google Scholar] [CrossRef]
- Tasseron, P.F.; van Emmerik, T.H.M.; Vriend, P.; Hauk, R.; Alberti, F.; Mellink, Y.; van der Ploeg, M. Defining plastic pollution hotspots. Sci. Total Environ. 2024, 934, 173294. [Google Scholar] [CrossRef]
- Roy, S.; Siracusa, V. Multifunctional Application of Biopolymers and Biomaterials. Int. J. Mol. Sci. 2023, 24, 10372. [Google Scholar] [CrossRef]
- Echeverría, C.; Muñoz-Bonilla, A.; Cuervo-Rodríguez, R.; López, D.; Fernández-García, M. Antibacterial PLA Fibers Containing Thiazolium Groups as Wound Dressing Materials. ACS Appl. Bio Mater. 2019, 2, 4714–4719. [Google Scholar] [CrossRef]
- Alexeeva, O.; Olkhov, A.; Konstantinova, M.; Podmasterev, V.; Tretyakov, I.; Petrova, T.; Koryagina, O.; Lomakin, S.; Siracusa, V.; Iordanskii, A.L. Improvement of the Structure and Physicochemical Properties of Polylactic Acid Films by Addition of Glycero-(9,10-trioxolane)-Trialeate. Polymers 2022, 14, 3478. [Google Scholar] [CrossRef]
- Ferreira, E.F.; Mouro, C.; Silva, L.; Gouveia, I.C. Sustainable Packaging Material Based on PCL Nanofibers and Lavandula luisieri Essential Oil, to Preserve Museological Textiles. Polymers 2022, 14, 597. [Google Scholar] [CrossRef] [PubMed]
- Shao, L.; Xi, Y.; Weng, Y. Recent Advances in PLA-Based Antibacterial Food Packaging and Its Applications. Molecules 2022, 27, 5953. [Google Scholar] [CrossRef]
- Motelica, L.; Ficai, D.; Ficai, A.; Oprea, O.C.; Kaya, D.A.; Andronescu, E. Biodegradable Antimicrobial Food Packaging: Trends and Perspectives. Foods 2020, 9, 1438. [Google Scholar] [CrossRef] [PubMed]
- Siracusa, V.; Rocculi, P.; Romani, S.; Dalla Rosa, M. Biodegradable Polymers for food packaging: A review. Trends Food Sci. Technol. 2008, 19, 634–643. [Google Scholar] [CrossRef]
- Olkhov, A.; Alexeeva, O.; Konstantinova, M.; Podmasterev, V.; Tyubaeva, P.; Borunova, A.; Siracusa, V.; Iordanskii, A.L. Effect of Glycero-(9,10-trioxolane)-trialeate on the Physicochemical Properties of Non-Woven Polylactic Acid Fiber Materials. Polymers 2021, 13, 2517. [Google Scholar] [CrossRef]
- Rojas, A.; Velásquez, E.; Patiño Vidal, C.; Guarda, A.; Galotto, M.J.; López de Dicastillo, C. Active PLA Packaging Films: Effect of Processing and the Addition of Natural Antimicrobials and Antioxidants on Physical Properties, Release Kinetics, and Compostability. Antioxidants 2021, 10, 1976. [Google Scholar] [CrossRef]
- Alexeeva, O.V.; Olkhov, A.A.; Konstantinova, M.L.; Podmasterev, V.V.; Petrova, T.V.; Martirosyan, L.Y.; Karyagina, O.K.; Kozlov, S.S.; Lomakin, S.M.; Tretyakov, I.V.; et al. A Novel Approach for Glycero-(9,10-trioxolane)-Trialeate Incorporation into Poly(lactic acid)/Poly(ε-caprolactone) Blends for Biomedicine and Packaging. Polymers 2024, 16, 128. [Google Scholar] [CrossRef] [PubMed]
- Castañeda-Rodríguez, S.; González-Torres, M.; Ribas-Aparicio, R.M.; Del Prado-Audelo, M.L.; Leyva-Gómez, G.; Gürer, E.S.; Sharifi-Rad, J. Recent advances in modified poly (lactic acid) as tissue engineering materials. J. Biol. Eng. 2023, 17, 21. [Google Scholar] [CrossRef]
- Acik, G. Preparation of antimicrobial and biodegradable hybrid soybean oil and poly (ʟ-lactide) based polymer with quaternized ammonium salt. Polym. Degrad. Stab. 2020, 181, 109317. [Google Scholar] [CrossRef]
- Qin, Y.; Liu, D.; Wu, Y.; Yuan, M.; Li, L.; Yang, J. Effect of PLA/PCL/cinnamaldehyde antimicrobial packaging on physicochemical and microbial quality of button mushroom (Agaricus bisporus). Postharvest Biol. Technol. 2015, 99, 73. [Google Scholar] [CrossRef]
- Gutiérrez, L.; Batlle, R.; Andújar, S.; Sánchez, C.; Nerín, C. Evaluation of antimicrobial active packaging to increase shelf life of gluten-free sliced bread. Packag. Technol. Sci. 2011, 24, 485–494. [Google Scholar] [CrossRef]
- Erdohan, Z.Ö.; Çam, B.; Turhan, K.N. Characterization of antimicrobial polylactic acid based films. J. Food Eng. 2013, 119, 308. [Google Scholar] [CrossRef]
- Tokiwa, Y.; Calabia, B.P. Biodegradability and biodegradation of poly(lactide). Appl. Microbiol. Biotechnol. 2006, 72, 244. [Google Scholar] [CrossRef] [PubMed]
- Siracusa, V. Microbial Degradation of Synthetic Biopolymers Waste. Polymers 2019, 11, 1066. [Google Scholar] [CrossRef]
- Omer, A.M.; Tamer, T.M.; Khalifa, R.E.; Eltaweil, A.S.; Agwa, M.M.; Sabra, S.; Abd-Elmonem, M.S.; Mohy-Eldin, M.S.; Ziora, Z.M. Formulation and Antibacterial Activity Evaluation of Quaternized Aminochitosan Membrane for Wound Dressing Applications. Polymers 2021, 13, 2428. [Google Scholar] [CrossRef]
- Singh, V.; Marimuthu, T.; Makatini, M.M.; Choonara, Y.E. Biopolymer-Based Wound Dressings with Biochemical Cues for Cell-Instructive Wound Repair. Polymers 2022, 14, 5371. [Google Scholar] [CrossRef]
- Mani, M.P.; Faudzi, A.A.M.; Ramakrishna, S.; Ismail, A.F.; Jaganathan, S.K.; Tucker, N.; Rathanasamy, R. Sustainable electrospun materials with enhanced blood compatibility for wound healing applications—A mini review: Curr. Opin. Biomed. Eng. 2023, 27, 100457. [Google Scholar] [CrossRef]
- Unnithan, A.R.; Barakat, N.A.M.; Tirupathi Pichiah, P.B.; Gnanasekaran, G.; Nirmala, R.; Cha, Y.-S.; Jung, C.-H.; El-Newehy, M.; Kim, H.Y. Wound-dressing materials with antibacterial activity from electrospun polyurethane–dextran nanofiber mats containing ciprofloxacin HCl. Carbohydr. Polym. 2012, 90, 1786. [Google Scholar] [CrossRef] [PubMed]
- Negut, I.; Grumezescu, V.; Grumezescu, A.M. Treatment Strategies for Infected Wounds. Molecules 2018, 23, 2392. [Google Scholar] [CrossRef] [PubMed]
- Subbuvel, M.; Kavan, P. Development and investigation of antibacterial and antioxidant characteristics of poly lactic acid films blended with neem oil and curcumin. J. Appl. Polym. Sci. 2021, 139, 51891. [Google Scholar] [CrossRef]
- Singh, A.A.; Sharma, S.; Srivastava, M.; Majumdar, A. Modulating the properties of polylactic acid for packaging applications using biobased plasticizers and naturally obtained fillers. Int. J. Biol. Macromol. 2020, 153, 1165–1175. [Google Scholar] [CrossRef]
- Ardjoum, N.; Chibani, N.; Shankar, S.; Fadhel, Y.B.; Djidjelli, H.; Lacroix, M. Development of antimicrobial films based on poly(lactic acid) incorporated with Thymus vulgaris essential oil and ethanolic extract of Mediterranean propolis. Int. J. Biol. Macromol. 2021, 185, 535–542. [Google Scholar] [CrossRef]
- Altun, E.; Yuca, E.; Ekren, N.; Kalaskar, D.M.; Ficai, D.; Dolete, G.; Ficai, A.; Gunduz, O. Kinetic Release Studies of Antibiotic Patches for Local Transdermal Delivery. Pharmaceutics 2021, 13, 613. [Google Scholar] [CrossRef] [PubMed]
- Smith, R.; Russo, J.; Fiegel, J.; Brogden, N. Antibiotic Delivery Strategies to Treat Skin Infections When Innate Antimicrobial Defense Fails. Antibiotics 2020, 9, 56. [Google Scholar] [CrossRef] [PubMed]
- Joy, N.; Samavedi, S. Identifying Specific Combinations of Matrix Properties that Promote Controlled and Sustained Release of a Hydrophobic Drug from Electrospun Meshes. ACS Omega 2020, 5, 15865–15876. [Google Scholar] [CrossRef]
- Ramos, M.; Fortunati, E.; Beltran, A.; Peltzer, M.; Cristofaro, F.; Visai, L.; Valente, A.J.M.; Jimenez, A.; Kenny, J.M.; Garrigos, M.C. Controlled Release, Disintegration, Antioxidant, and Antimicrobial Properties of Poly (Lactic Acid)/Thymol/Nanoclay Composites. Polymers 2020, 12, 1878. [Google Scholar] [CrossRef]
- Iordanskii, A.L.; Zaikov, G.E.; Berlin, A.A. Diffusion kinetics of hydrolysis of biodegradable polymers. Weight loss and control of the release of low molecular weight substances. Polym. Sci. Ser. D 2015, 8, 211–218. [Google Scholar] [CrossRef]
- Soares, J.S.; Zunino, P. A mixture model for water uptake, degradation, erosion and drug release from polydisperse polymeric networks. Biomaterials 2010, 31, 3032–3042. [Google Scholar] [CrossRef]
- Peppas, N.A. A model of dissolution-controlled solute release from porous drug delivery polymeric systems. J. Biomed. Mater. Res. 1983, 17, 1079–1087. [Google Scholar] [CrossRef] [PubMed]
- Sevim, K.; Pan, J. A model for hydrolytic degradation and erosion of biodegradable polymers. Acta Biomater. 2018, 66, 192–199. [Google Scholar] [CrossRef]
- Feldstein, M.M.; Raigorodskii, I.M.; Iordanskii, A.L.; Hadgraft, J. Modeling of percutaneous drug transport in vitro using skin-imitating Carbosil membrane. J. Control. Release 1998, 52, 25. [Google Scholar] [CrossRef]
- Iordanskii, A.; Karpova, S.; Olkhov, A.; Borovikov, P.; Kildeeva, N.; Liu, Y. Structure-morphology impact upon segmental dynamics and diffusion in the biodegradable ultrafine fibers of polyhydroxybutyrate-polylactide blends. Eur. Polym. J. 2019, 117, 208. [Google Scholar] [CrossRef]
- Lomakin, S.; Mikheev, Y.; Usachev, S.; Rogovina, S.; Zhorina, L.; Perepelitsina, E.; Levina, I.; Kuznetsova, O.; Shilkina, N.; Iordanskii, A.; et al. Evaluation and Modeling of Polylactide Photodegradation under Ultraviolet Irradiation: Bio-Based Polyester Photolysis Mechanism. Polymers 2024, 16, 985. [Google Scholar] [CrossRef] [PubMed]
- Crank, J. The Mathematics of Diffusion, 2nd ed.; Oxford University Press: Oxford, UK, 1975; ISBN 0198533446. [Google Scholar]
- Siepmann, J.; Peppas, N.A. Higuchi equation: Derivation, applications, use and misuse. Int. J. Pharm. 2011, 418, 6. [Google Scholar] [CrossRef] [PubMed]
- Korsmeyer, R.W.; Gurny, R.; Doelker, E.; Buri, P.; Peppas, N.A. Mechanisms of solute release from porous hydrophilic polymers. Int. J. Pharm. 1983, 15, 25. [Google Scholar] [CrossRef]
- Zhu, W.; Long, J.; Shi, M. Release Kinetics Model Fitting of Drugs with Different Structures from Viscose Fabric. Materials 2023, 16, 3282. [Google Scholar] [CrossRef] [PubMed]
- Han, J.H.; Floros, J.D. Casting Antimicrobial Packaging Films and Measuring Their Physical Properties and Antimicrobial Activity. J. Plast. Film Sheeting 1997, 13, 287. [Google Scholar] [CrossRef]
- Li, S.; McCarthy, S. Further investigations on the hydrolytic degradation of poly (DL-lactide). Biomaterials 1999, 20, 35–44. [Google Scholar] [CrossRef]
- Balouiri, M.; Sadiki, M.; Ibnsouda, S.K. Methods for in vitro evaluating antimicrobial activity: A review. J. Pharm. Anal. 2016, 6, 71–79. [Google Scholar] [CrossRef]
- Murray, P.R.; Jo, E.; Turnidge, B. Manual of Clinical Microbiology, 9th ed.; ASM Press: Washington, DC, USA, 2007; pp. 1152–1172. [Google Scholar]
- Clinical and Laboratory Standards Institute (CLSI). Performance Standards for Antimicrobial Disk Susceptibility Tests; Approved Standard, 11th ed.; CLSI document M02-A11; Clinical and Laboratory Standards Institute: Wayne, PA, USA, 2012; Volume 32, p. 13. ISBN 1-56238-782-0. [Google Scholar]
- Clinical and Laboratory Standards Institute (CLSI). Method for Antifungal Disk Diffusion Susceptibility Testing of Yeasts; Approved Guideline, 2nd ed.; CLSI Document M44-A2; Clinical and Laboratory Standards Institute: Wayne, PA, USA, 2009; Volume 29, p. 6. ISBN 1-56238-703-0. [Google Scholar]
- Rothstein, S.N.; Federspiel, W.J.; Little, S.R. A unified mathematical model for the prediction of controlled release from surface and bulk eroding polymer matrices. Biomaterials 2009, 30, 1657. [Google Scholar] [CrossRef] [PubMed]
- Masters, D.B.; Berde, C.B.; Dutta, S.; Turek, T.; Langer, R. Sustained local anesthetic release from bioerodible polymer matrices: A potential method for prolonged regional anesthesia. Pharm. Res. 1993, 10, 1527. [Google Scholar] [CrossRef]
- Laracuente, M.-L.; Yu, M.H.; McHugh, K.J. Zero-order drug delivery: State of the art and future prospects. J. Control. Release 2020, 327, 834. [Google Scholar] [CrossRef]
- Song, Z.; Li, X.; Wu, K.; Cai, S. Nonequilibrium thermodynamic modeling of case II diffusion in glassy polymers. J. Mech. Phys. Solids 2023, 179, 105395. [Google Scholar] [CrossRef]
- Park, K.; Skidmore, S.; Hadar, J.; Garner, J.; Park, H.; Otte, A.; Soh, B.K.; Yoon, G.; Yu, D.; Yun, Y.; et al. Injectable, long-acting PLGA formulations: Analyzing PLGA and understanding microparticle formation. J. Control. Release 2019, 304, 125. [Google Scholar] [CrossRef]
- Dekyndt, B.; Verin, J.; Neut, C.; Siepmann, F.; Siepmann, J. How to easily provide zero order release of freely soluble drugs from coated pellets. Int. J. Pharm. 2015, 478, 31. [Google Scholar] [CrossRef]
- Li, S.; Garreau, H.; Vert, M. Structure-property relationships in the case of the degradation of massive poly(α-hydroxy acids) in aqueous media. J. Mater. Sci. Mater. Med. 1990, 1, 198–206. [Google Scholar] [CrossRef]
- Mengjiao, Z.; Sitong, Y.; Qingxiu, J. Degradation Performance of Electrospun Polylactic Acid/Cellulose Nanocrystalline Composite Fiber Membrane. Journal of Physics: Conference Series 2019, 1168, 022072. [Google Scholar] [CrossRef]
- Qin, L.; Qiu, J.; Liu, M.; Ding, S.; Shao, L.; Lü, S.; Zhang, G.; Zhao, Y.; Fu, X. Mechanical and thermal properties of poly(lactic acid) composites with rice straw fibermodified by poly(butyl acrylate), Chem. Eng. J. 2011, 166, 772–778. [Google Scholar] [CrossRef]
- Chen, C.; Chueh, Y.; Tseng, H.; Huang, M.; Lee, Y. Preparation and characterization of biodegradable PLA polymeric blends. Biomaterials 2003, 24, 1167–1173. [Google Scholar] [CrossRef]
- Qu, P.; Gao, Y.; Wu, G.; Zhang, L. Nanocomposite of poly(lactid acid) reinforced with cellulose nanofibrils. BioResources 2010, 5, 1811–1823. [Google Scholar] [CrossRef]
- Chieng, B.W.; Ibrahim, N.A.; Then, Y.Y.; Loo, Y.Y. Epoxidized Vegetable Oils Plasticized Poly(lactic acid) Biocomposites: Mechanical, Thermal and Morphology Properties. Molecules 2014, 19, 16024–16038. [Google Scholar] [CrossRef]
- Moliner, C.; Finocchio, E.; Arato, E.; Ramis, G.; Lagazzo, A. Influence of the Degradation Medium on Water Uptake, Morphology, and Chemical Structure of Poly(Lactic Acid)-Sisal Bio-Composites. Materials 2020, 13, 3974. [Google Scholar] [CrossRef]
- Farid, T.; Herrera, V.N.; Kristiina, O. Investigation of crystalline structure of plasticized poly (lactic acid)/Banana nanofibers composites. IOP Conf. Ser. Mater. Sci. Eng. 2018, 369, 012031. [Google Scholar] [CrossRef]
- Song, Y.; Tashiro, K.; Xu, D.; Liu, J.; Bin, Y. Crystallization behavior of poly(lactic acid)/microfibrillated cellulose composite, Polymer 2013, 54, 3417–3425. [CrossRef]
- Pan, P.; Zhu, B.; Kai, W.; Dong, T.; Inoue, Y. Polymorphic Transition in Disordered Poly(l-lactide) Crystals Induced by Annealing at Elevated Temperatures. Macromolecules 2008, 41, 4296–4304. [Google Scholar] [CrossRef]
- Luo, Y.; Lin, Z.; Guo, G. Biodegradation Assessment of Poly (Lactic Acid) Filled with Functionalized Titania Nanoparticles (PLA/TiO2) under Compost Conditions. Nanoscale Res. Lett. 2019, 14, 56. [Google Scholar] [CrossRef] [PubMed]
- Giuliana, G.; Roberto, P. Effect of PLA grades and morphologies on hydrolytic degradation at composting temperature: Assessment of structural modification and kinetic parameters. Polym. Degrad. Stab. 2013, 98, 1006–1014. [Google Scholar] [CrossRef]
- Kolstad, J. Crystallization kinetics of poly(L-lactideco-meso-lactide). J. Appl. Polym. Sci. 1996, 62, 1079–1091. [Google Scholar] [CrossRef]
- Ljungberg, N.; Wesslén, B. The effects of plasticizers on the dynamic mechanical and thermal properties of poly(lactic acid). J. Appl. Polym. Sci. 2002, 86, 1227–1234. [Google Scholar] [CrossRef]
- Inácio, E.M.; Lima, M.C.P.; Souza, D.H.S.; Sirelli, L.; Dias, M.L. Crystallization, thermal and mechanical behavior of oligosebacate plasticized poly(lactic acid) films. Polymer 2018, 28, 381–388. [Google Scholar] [CrossRef]
- Lekhniuk, N.; Fesenko, U.; Pidhirnyi, Y.; Sekowska, A.; Korniychuk, O.; Konechnyi, Y. Raoultella terrigena: Current state of knowledge, after two recently identified clinical cases in Eastern Europe. Clin. Case Rep. 2021, 9, e04089. [Google Scholar] [CrossRef]
- Poirel, L.; Madec, J.Y.; Lupo, A.; Schink, A.K.; Kieffer, N.; Nordmann, P.; Schwarz, S. Antimicrobial Resistance in Escherichia coli. Microbiol. Spectr. 2018, 6. [Google Scholar] [CrossRef] [PubMed]
- Bao, L.; Peng, R.; Ren, X.; Ma, R.; Li, J.; Wang, Y. Analysis of some common pathogens and their drug resistance to antibiotics. Pak. J. Med. Sci. 2013, 29, 135. [Google Scholar] [CrossRef]
- Ugazio, E.; Tullio, V.; Binello, A.; Tagliapietra, S.; Dosio, F. Ozonated Oils as Antimicrobial Systems in Topical Applications. Their Characterization, Current Applications, and Advances in Improved Delivery Techniques. Molecules 2020, 25, 334. [Google Scholar] [CrossRef]
- Moureu, S.; Violleau, F.; Haimoud-Lekhal, D.A.; Calmon, A. Ozonation of sunflower oils: Impact of experimental conditions on the composition and the antibacterial activity of ozonized oils. Chem. Phys. Lipids 2015, 186, 79–85. [Google Scholar] [CrossRef]
- de Almeida Kogawa, R.N.; de Arruda, E.J.; Micheletti, A.C.; Cepa Matos, M.d.F.; Silva de Oliveira, L.C.; de Lima, D.P.; Pereira Carvalho, N.C.; de Oliveira, P.D.; de Castro Cunha, M.; Ojeda, M.; et al. Synthesis, characterization, thermal behavior and biological activity of ozonides from vegetable oils. RSC Adv. 2015, 5, 65427–65436. [Google Scholar] [CrossRef]
- Puxeddu, S.; Scano, A.; Scorciapino, M.A.; Delogu, I.; Vascellari, S.; Ennas, G.; Manzin, A.; Angius, F. Physico-Chemical Investigation and Antimicrobial Efficacy of Ozonated Oils: The Case Study of Commercial Ozonated Olive and Sunflower Seed Refined Oils. Molecules 2024, 29, 679. [Google Scholar] [CrossRef]
- Kalın, G.; Alp, E.; Chouaikhi, A.; Roger, C. Antimicrobial Multidrug Resistance: Clinical Implications for Infection Management in Critically Ill Patients. Microorganisms 2023, 11, 2575. [Google Scholar] [CrossRef]
- Han, S.; Fisher, J.P.; Mikos, A.G.; Hogan, K.J. Polymeric nanomaterials in 3D bioprinting for tissue engineering and drug delivery applications. Bioprinting 2024, 40, e00345. [Google Scholar] [CrossRef]
- Puri, S.; Mazza, M.; Roy, G.; England, R.M.; Zhou, L.; Nourian, S.; Subramony, J.A. Evolution of nanomedicine formulations for targeted delivery and controlled release. Adv. Drug Deliv. Rev. 2023, 200, 114962. [Google Scholar] [CrossRef] [PubMed]
- Dong, Y.; Jiang, T.; Wu, T.; Wang, W.; Xie, Z.; Yu, X.; Peng, Y.; Wang, L.; Xiao, Y.; Zhong, T. Enzyme-responsive controlled-release materials for food preservation and crop protection—A review. Int. J. Biol. Macromol. 2024, 254, 128051. [Google Scholar] [CrossRef]
- Ćorović, M.; Milivojević, A.; Simović, M.; Banjanac, K.; Pjanović, R.; Bezbradica, D. Enzymatically derived oil-based L-ascorbyl esters: Synthesis, antioxidant properties and controlled release from cosmetic formulations. Sustain. Chem. Pharm. 2020, 15, 100231. [Google Scholar] [CrossRef]
- Zhao, S.; Li, L.; Wang, Y.; Liu, Z.; Yang, S.; Gao, X.; Zhang, C.; Yu, A. Remediation of petroleum-contaminated site soil by bioaugmentation with immobilized bacterial pellets stimulated by a controlled-release oxygen composite. Environ. Pollut. 2024, 356, 124253. [Google Scholar] [CrossRef] [PubMed]
- Zare, I.; Chevrier, D.M.; Cifuentes-Rius, A. Protein-protected metal nanoclusters as diagnostic and therapeutic platforms for biomedical applications. Mater. Today 2023, 66, 159. [Google Scholar] [CrossRef]
- Raghuvanshi, S.; Khan, H.; Saroha, V.; Sharma, H.; Gupta, H.S.; Kadam, A.; Dutt, D. Recent advances in biomacromolecule-based nanocomposite films for intelligent food packaging—A review. Int. J. Biol. Macromol. 2023, 253, 127420. [Google Scholar] [CrossRef]

| Sample | Opacity (mm−1) | Film Thickness (µm) |
|---|---|---|
| PLA | 0.25 ± 0.03 | 126.0 ± 3.5 |
| PLA 4100 min | 0.83 ± 0.05 | 123.5 ± 3.5 |
| PLA 6100 min | 1.23 ± 0.06 | 125.0 ± 3.7 |
| PLA + 50% OTOA | 0.98 ± 0.04 | 139.5 ± 2.2 |
| PLA + OTOA 50% 4100 min | 1.68 ± 0.05 | 143.0 ± 2.8 |
| PLA + OTOA 50% 6100 min | 2.5 ± 0.07 | 146.0 ± 3.0 |
| PLA Characteristic Bands, cm−1 | PLA + 50% OTOA Characteristic Bands, cm−1 | Characteristic Band Assignment |
|---|---|---|
| 3100–3620 (observed after hydr.) | 3100–3620 (after hydr.) | -OH |
| 2996 | 2995 | -CH3 (asim) |
| 2945 | - | -CH (sim) |
| - | 2927 | -CH2 (asim) |
| 2880 | - | - CH3 stretching |
| 2857 (after hydr.) | 2856 (OTOA) | -CH2 (sim) |
| 1753 | 1753 | -C=O stretching |
| - | 1540 (after hydr.) | -COO |
| - | 1576 (after hydr.) | -COO |
| 1455 | 1455 | –CH3 bending |
| Sample | χ (XRD), (%) |
|---|---|
| PLA | 35.5 |
| PLA 6100 min NaCl | 31.3 |
| PLA + 50% OTOA | 24.3 |
| PLA + 50% OTOA 4100 min NaCl | 32.3 |
| PLA + 50% OTOA 6100 min NaCl | 32.6 |
| Sample | Tm (°C) | ∆Hm (J/g) | β | χ (DSC) (%) |
|---|---|---|---|---|
| PLA | 169.2 | 39.6 | 0 | 42.2 |
| PLA 6100 min | 169.6 | 35.8 | 0 | 38.3 |
| PLA + 50% OTOA | 159.1 * | 11.8 * | 0.5 | 25.2 |
| PLA + OTOA 50% 6100 min | 158.3 * | 23.9 * | 0.25 ** | 34.0 |
| Sample | Bacterial Strain | |
|---|---|---|
| R. terrigena (Klebsiella terrigena) | E. coli | |
| Size of Clear Zone (mm) | ||
| Reference PLA | 0.0 ± 0.0 | 0.0 ± 0.0 |
| PLA + 50% OTOA | 29.2 ± 0.4 | 27.2 ± 0.2 |
| OTOA * | 31.2 ± 0.1 | 29.0 ± 0.1 |
Disclaimer/Publisher’s Note: The statements, opinions and data contained in all publications are solely those of the individual author(s) and contributor(s) and not of MDPI and/or the editor(s). MDPI and/or the editor(s) disclaim responsibility for any injury to people or property resulting from any ideas, methods, instructions or products referred to in the content. |
© 2024 by the authors. Licensee MDPI, Basel, Switzerland. This article is an open access article distributed under the terms and conditions of the Creative Commons Attribution (CC BY) license (https://creativecommons.org/licenses/by/4.0/).
Share and Cite
Alexeeva, O.V.; Konstantinova, M.L.; Siracusa, V.; Podmasterev, V.V.; Martirosyan, L.Y.; Karyagina, O.K.; Kozlov, S.S.; Lomakin, S.M.; Tretyakov, I.V.; Petrova, T.V.; et al. Characterization and Evaluation of Zero-Order Release System Comprising Glycero-(9,10-trioxolane)-trialeate and PLA: Opportunity for Packaging and Biomedicine Applications. Polymers 2024, 16, 3554. https://doi.org/10.3390/polym16243554
Alexeeva OV, Konstantinova ML, Siracusa V, Podmasterev VV, Martirosyan LY, Karyagina OK, Kozlov SS, Lomakin SM, Tretyakov IV, Petrova TV, et al. Characterization and Evaluation of Zero-Order Release System Comprising Glycero-(9,10-trioxolane)-trialeate and PLA: Opportunity for Packaging and Biomedicine Applications. Polymers. 2024; 16(24):3554. https://doi.org/10.3390/polym16243554
Chicago/Turabian StyleAlexeeva, Olga V., Marina L. Konstantinova, Valentina Siracusa, Vyacheslav V. Podmasterev, Levon Yu. Martirosyan, Olga K. Karyagina, Sergey S. Kozlov, Sergey M. Lomakin, Ilya V. Tretyakov, Tuyara V. Petrova, and et al. 2024. "Characterization and Evaluation of Zero-Order Release System Comprising Glycero-(9,10-trioxolane)-trialeate and PLA: Opportunity for Packaging and Biomedicine Applications" Polymers 16, no. 24: 3554. https://doi.org/10.3390/polym16243554
APA StyleAlexeeva, O. V., Konstantinova, M. L., Siracusa, V., Podmasterev, V. V., Martirosyan, L. Y., Karyagina, O. K., Kozlov, S. S., Lomakin, S. M., Tretyakov, I. V., Petrova, T. V., & Iordanskii, A. L. (2024). Characterization and Evaluation of Zero-Order Release System Comprising Glycero-(9,10-trioxolane)-trialeate and PLA: Opportunity for Packaging and Biomedicine Applications. Polymers, 16(24), 3554. https://doi.org/10.3390/polym16243554









